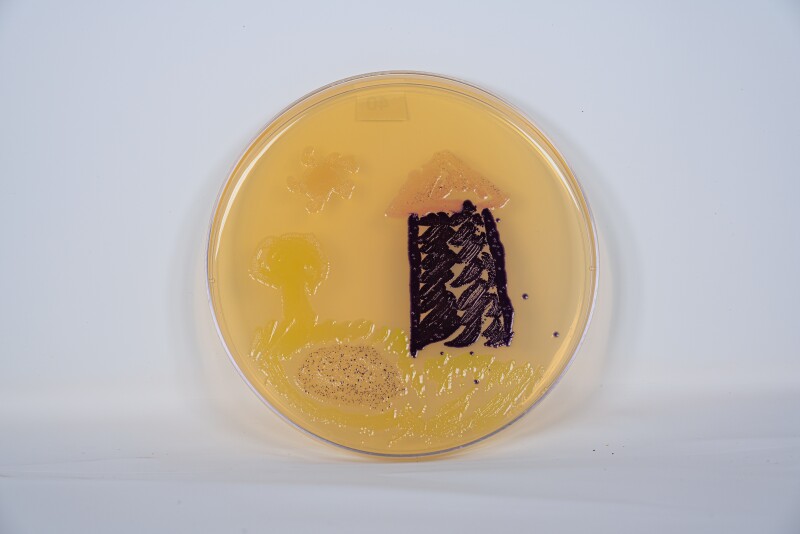
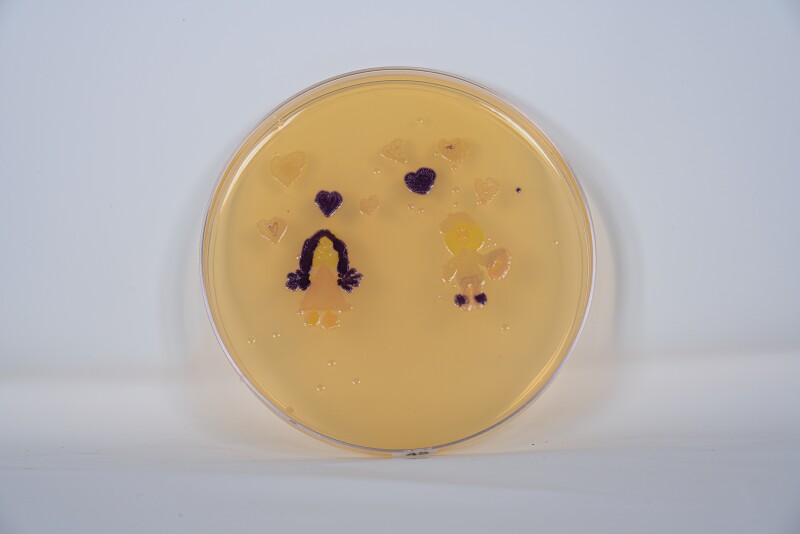
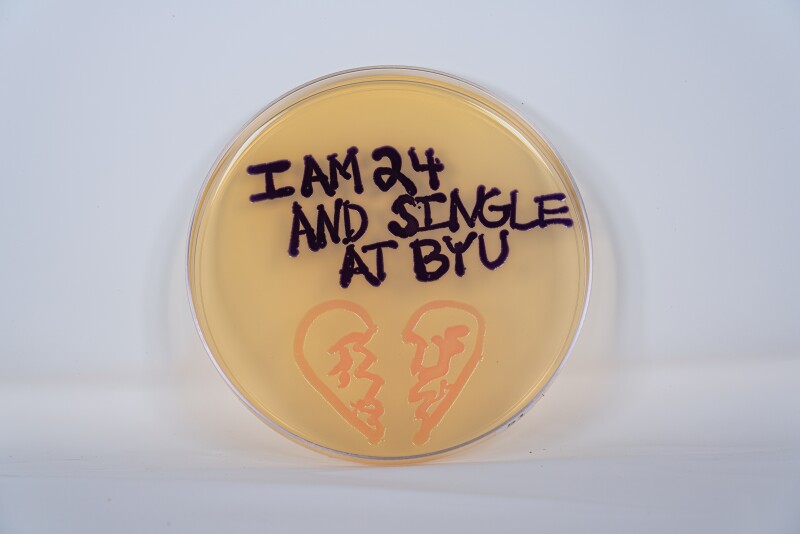
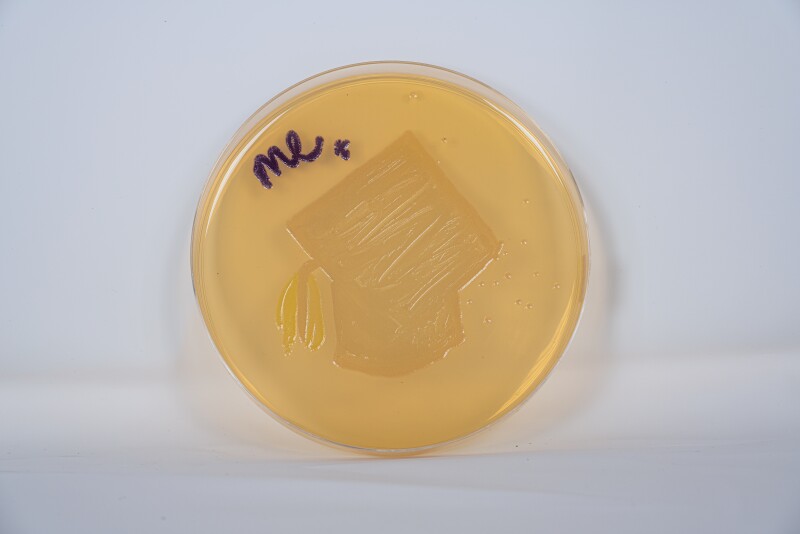
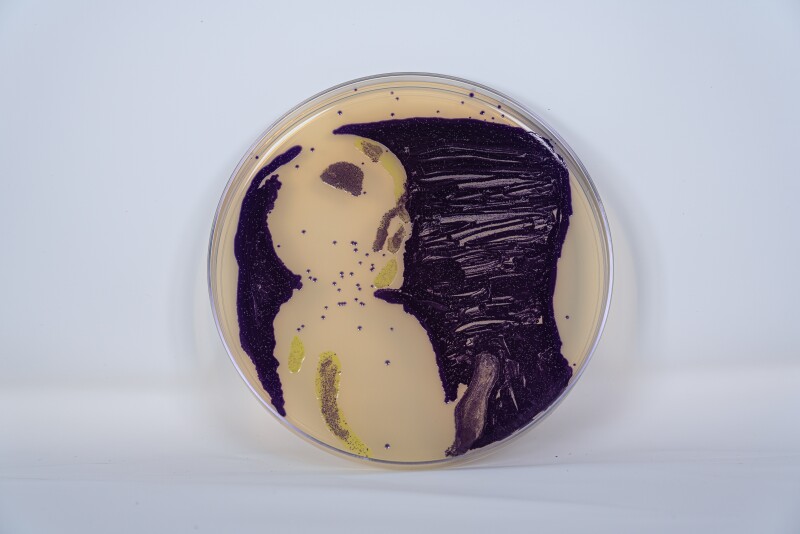
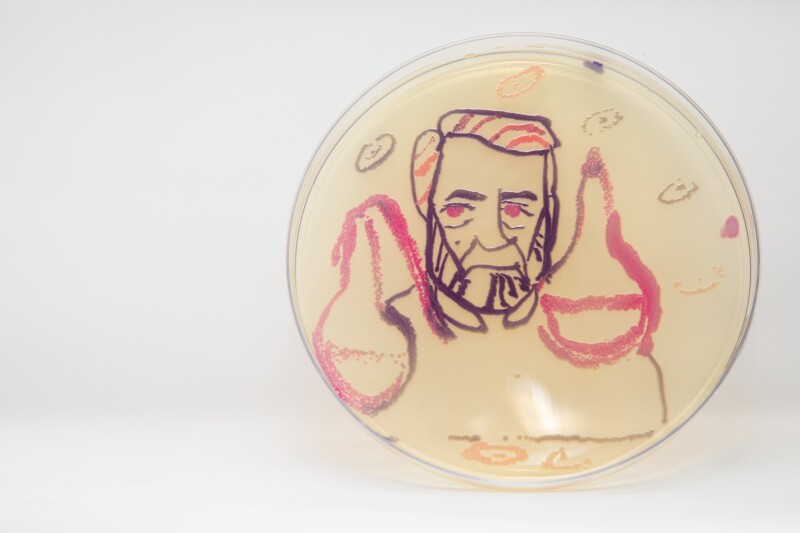
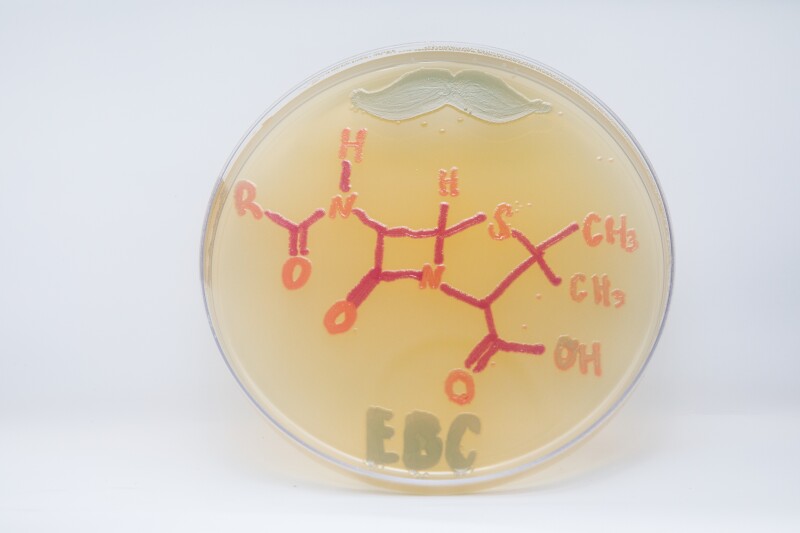
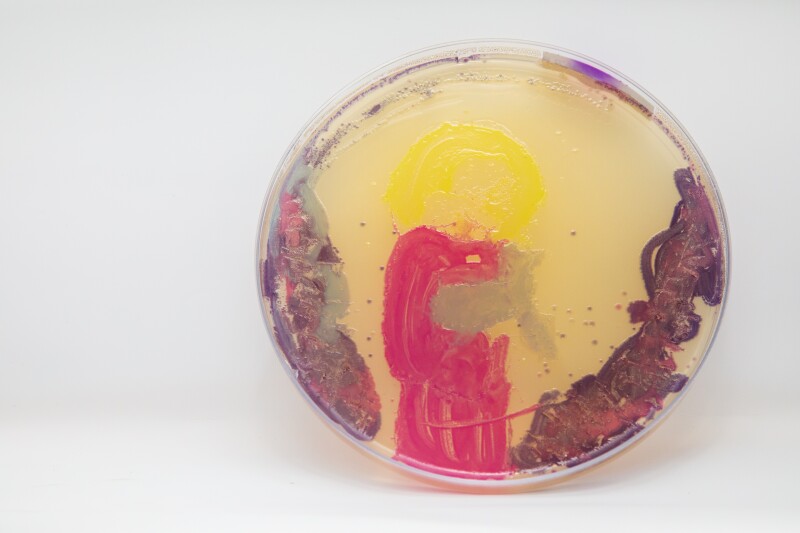
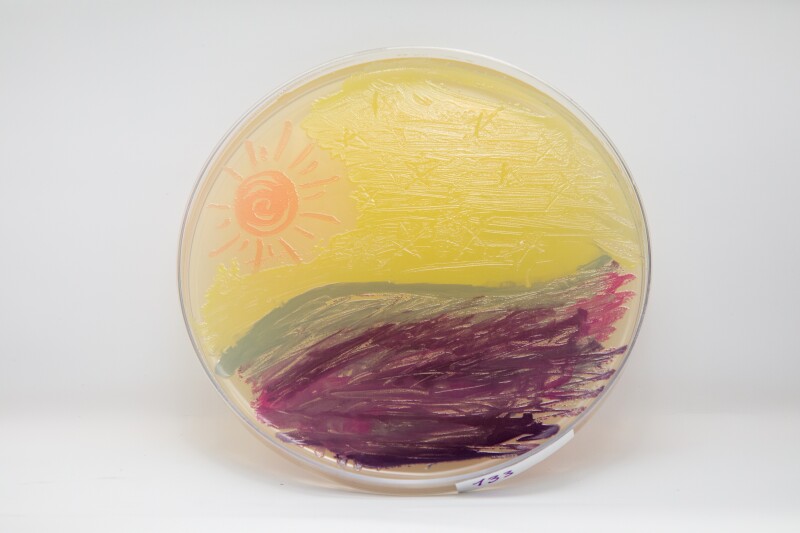
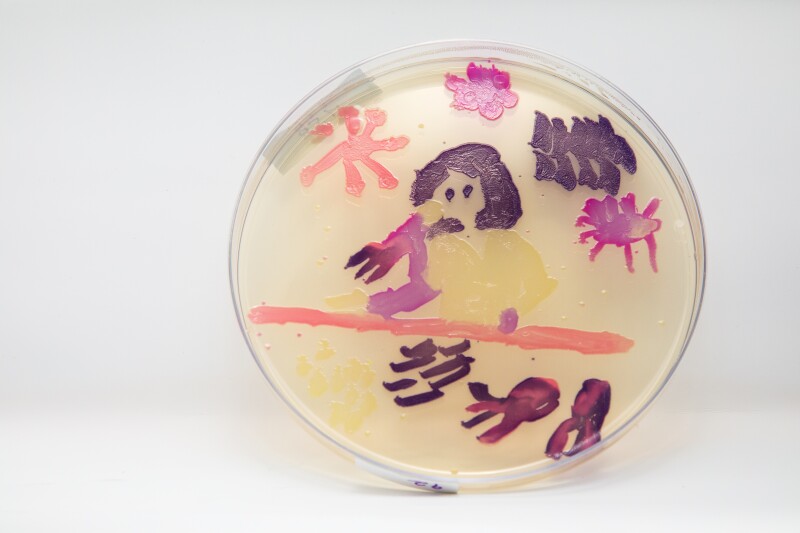
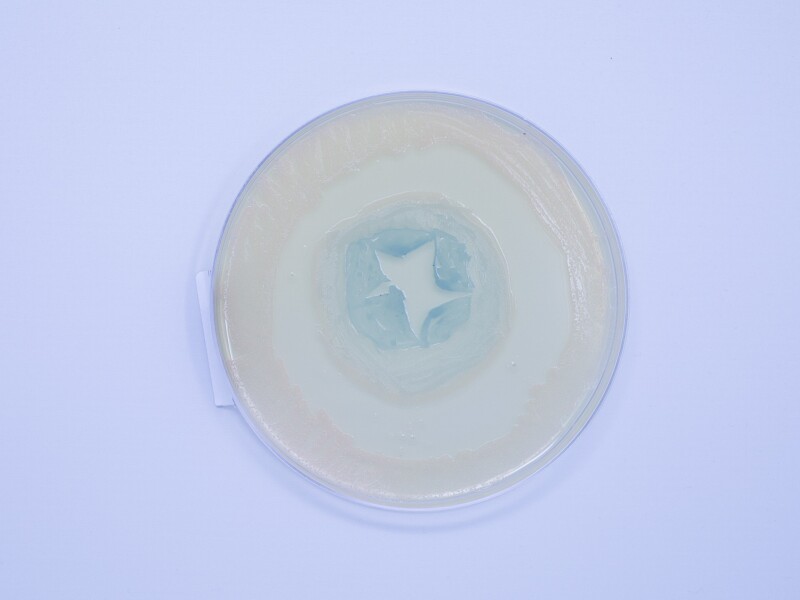
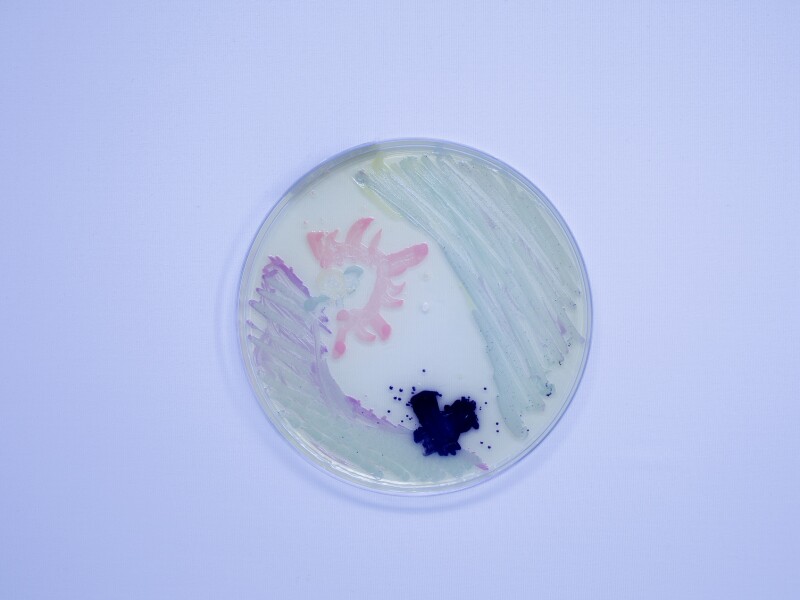
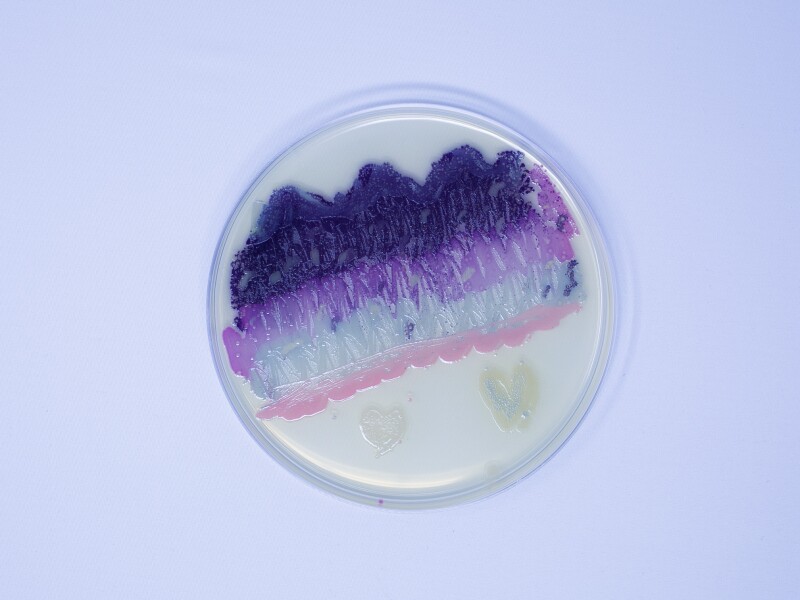
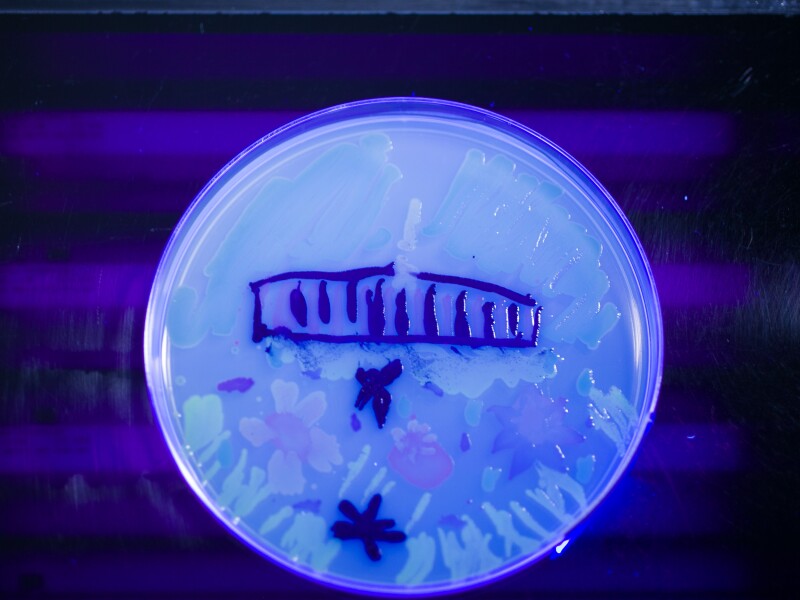
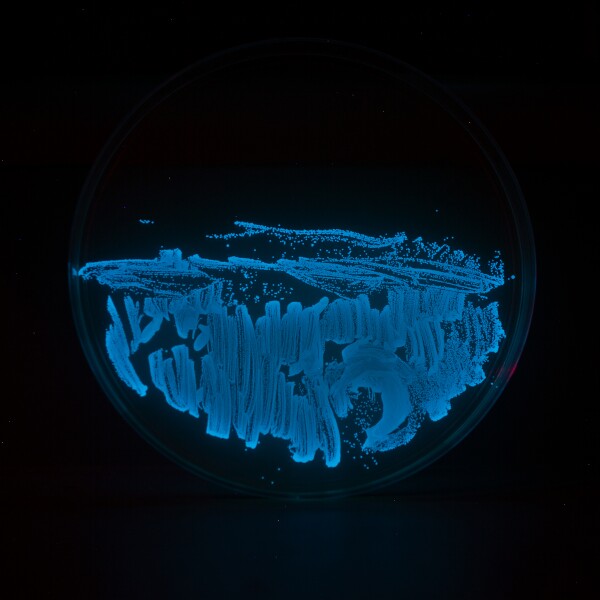

Agar Art Archive
Below are past contests and the beautiful work provided by the BYU community. If your art is not shown below, please contact the MMBio office and we will send it to you!
Want to navigate to a specific year? Click the links below!
Agar Art Fall 2024 - What Brings You Joy?

1 of 165
“Christ Holding Follower” by Lynette Juarez - 1st Place
“Christ Holding Follower” by Lynette Juarez - 1st Place

2 of 165
“More Than Endorphins” by Rebecca Gearhart - 2nd Place
“More Than Endorphins” by Rebecca Gearhart - 2nd Place

3 of 165
“Truth & Love” by Amy Bown - 3rd Place
“Truth & Love” by Amy Bown - 3rd Place

4 of 165
Honorable Mention
Honorable Mention

5 of 165
Honorable Mention
Honorable Mention

6 of 165
Honorable Mention
Honorable Mention

7 of 165
Honorable Mention
Honorable Mention

8 of 165
Honorable Mention
Honorable Mention

9 of 165
Honorable Mention
Honorable Mention

10 of 165
Honorable Mention
Honorable Mention

11 of 165
Honorable Mention
Honorable Mention

12 of 165
Honorable Mention
Honorable Mention

13 of 165
Honorable Mention
Honorable Mention

14 of 165
20241016_153058.jpg

15 of 165
20241016_153243.jpg

16 of 165
20241016_153320.jpg

17 of 165
20241016_153346.jpg

18 of 165
20241016_153412.jpg

19 of 165
20241016_153511.jpg

20 of 165
20241016_153543.jpg

21 of 165
20241016_153615.jpg

22 of 165
20241016_153706.jpg

23 of 165
20241016_153739.jpg

24 of 165
20241016_153816.jpg

25 of 165
20241016_153842.jpg

26 of 165
20241016_153957.jpg

27 of 165
20241016_154034.jpg

28 of 165
20241016_154104.jpg

29 of 165
20241016_154134.jpg

30 of 165
20241016_154206.jpg

31 of 165
20241016_154305.jpg

32 of 165
20241016_154358.jpg

33 of 165
20241016_154443.jpg

34 of 165
20241016_154516.jpg

35 of 165
20241016_154549.jpg

36 of 165
20241016_154630.jpg

37 of 165
Agar 122 Lab-01.jpg

38 of 165
Agar 122 Lab-02.jpg

39 of 165
Agar 122 Lab-03.jpg

40 of 165
Agar 122 Lab-04.jpg

41 of 165
Agar 122 Lab-05.jpg

42 of 165
Agar 122 Lab-06.jpg

43 of 165
Agar 122 Lab-07.jpg

44 of 165
Agar 122 Lab-08.jpg

45 of 165
Agar 122 Lab-09.jpg

46 of 165
Agar 122 Lab-10.jpg

47 of 165
Agar 122 Lab-11.jpg

48 of 165
Agar 122 Lab-12.jpg

49 of 165
Agar 122 Lab-13.jpg

50 of 165
Agar 122 Lab-14.jpg

51 of 165
Agar 122 Lab-15.jpg

52 of 165
Agar 122 Lab-16.jpg

53 of 165
Agar 122 Lab-17.jpg

54 of 165
Agar 122 Lab-18.jpg

55 of 165
Agar 122 Lab-19.jpg

56 of 165
Agar 122 Lab-20.jpg

57 of 165
Agar 122 Lab-21.jpg

58 of 165
Agar 122 Lab-22.jpg

59 of 165
Agar 122 Lab-23.jpg

60 of 165
Agar 122 Lab-24.jpg

61 of 165
Agar 122 Lab-25.jpg

62 of 165
Agar 122 Lab-26.jpg

63 of 165
Agar 122 Lab-27.jpg

64 of 165
Agar 122 Lab-28.jpg

65 of 165
Agar 122 Lab-30.jpg

66 of 165
Agar 122 Lab-32.jpg

67 of 165
Agar 122 Lab-33.jpg

68 of 165
Agar 122 Lab-34.jpg

69 of 165
Agar 122 Lab-35.jpg

70 of 165
Agar 122 Lab-36.jpg

71 of 165
Agar 122 Lab-37.jpg

72 of 165
Agar 122 Lab-38.jpg

73 of 165
Agar 122 Lab-39.jpg

74 of 165
Agar 122 Lab-40.jpg

75 of 165
Agar 122 Lab-42.jpg

76 of 165
Agar 122 Lab-43.jpg

77 of 165
Agar 122 Lab-44.jpg

78 of 165
Agar 122 Lab-45.jpg

79 of 165
Agar 122 Lab-46.jpg

80 of 165
Agar 122 Lab-47.jpg

81 of 165
Agar 122 Lab-48.jpg

82 of 165
Agar 122 Lab-49.jpg

83 of 165
Agar 122 Lab-50.jpg

84 of 165
Agar 122 Lab-51.jpg

85 of 165
Agar 122 Lab-52.jpg

86 of 165
Agar 122 Lab-53.jpg

87 of 165
Agar 122 Lab-54.jpg

88 of 165
Agar 122 Lab-55.jpg

89 of 165
Agar 122 Lab-57.jpg

90 of 165
Agar 122 Lab-58.jpg

91 of 165
Agar 122 Lab-59.jpg

92 of 165
Agar 122 Lab-60.jpg

93 of 165
Agar 122 Lab-61.jpg

94 of 165
Agar Fall 2024-01.jpg

95 of 165
Agar Fall 2024-03.jpg

96 of 165
Agar Fall 2024-04.jpg

97 of 165
Agar Fall 2024-05.jpg

98 of 165
Agar Fall 2024-06.jpg

99 of 165
Agar Fall 2024-07.jpg

100 of 165
Agar Fall 2024-08.jpg

101 of 165
Agar Fall 2024-10.jpg

102 of 165
Agar Fall 2024-11.jpg

103 of 165
Agar Fall 2024-12.jpg

104 of 165
Agar Fall 2024-13.jpg

105 of 165
Agar Fall 2024-14.jpg

106 of 165
Agar Fall 2024-15.jpg

107 of 165
Agar Fall 2024-16.jpg

108 of 165
Agar Fall 2024-17.jpg

109 of 165
Agar Fall 2024-18.jpg

110 of 165
Agar Fall 2024-19.jpg

111 of 165
Agar Fall 2024-20.jpg

112 of 165
Agar Fall 2024-21.jpg

113 of 165
Agar Fall 2024-22.jpg

114 of 165
Agar Fall 2024-23.jpg

115 of 165
Agar Fall 2024-24.jpg

116 of 165
Agar Fall 2024-25.jpg

117 of 165
Agar Fall 2024-26.jpg

118 of 165
Agar Fall 2024-27.jpg

119 of 165
Agar Fall 2024-28.jpg

120 of 165
Agar Fall 2024-30.jpg

121 of 165
Agar Fall 2024-31.jpg

122 of 165
Agar Fall 2024-32.jpg

123 of 165
Agar Fall 2024-33.jpg

124 of 165
Agar Fall 2024-34.jpg

125 of 165
Agar Fall 2024-35.jpg

126 of 165
Agar Fall 2024-36.jpg

127 of 165
Agar Fall 2024-37.jpg

128 of 165
Agar Fall 2024-38.jpg

129 of 165
Agar Fall 2024-39.jpg

130 of 165
Agar Fall 2024-40.jpg

131 of 165
Agar Fall 2024-41.jpg

132 of 165
Agar Fall 2024-42.jpg

133 of 165
Agar Fall 2024-43.jpg

134 of 165
Agar Fall 2024-44.jpg

135 of 165
Agar Fall 2024-45.jpg

136 of 165
Agar Fall 2024-46.jpg

137 of 165
Agar Fall 2024-47.jpg

138 of 165
Agar Fall 2024-48.jpg

139 of 165
Agar Fall 2024-49.jpg

140 of 165
Agar Fall 2024-50.jpg

141 of 165
Agar Fall 2024-51.jpg

142 of 165
Agar Fall 2024-52.jpg

143 of 165
Agar Fall 2024-53.jpg

144 of 165
Agar Fall 2024-54.jpg

145 of 165
Agar Fall 2024-55.jpg

146 of 165
Agar Fall 2024-56.jpg

147 of 165
Agar Fall 2024-58.jpg

148 of 165
Agar Fall 2024-59.jpg

149 of 165
Agar Fall 2024-60.jpg

150 of 165
Agar Fall 2024-61.jpg

151 of 165
Agar Fall 2024-62.jpg

152 of 165
Agar Fall 2024-63.jpg

153 of 165
Agar Fall 2024-64.jpg

154 of 165
Agar Fall 2024-65.jpg

155 of 165
Agar Fall 2024-66.jpg

156 of 165
Agar Fall 2024-68.jpg

157 of 165
Agar Fall 2024-69.jpg

158 of 165
Agar Fall 2024-72.jpg

159 of 165
Agar Fall 2024-73.jpg

160 of 165
Agar Fall 2024-74.jpg

161 of 165
Agar Fall 2024-75.jpg

162 of 165
Agar Fall 2024-77.jpg

163 of 165
Agar Fall 2024-78.jpg

164 of 165
Agar Fall 2024-79.jpg

165 of 165
Agar Fall 2024-80.jpg
1
of
165
Agar Art Fall 2023 - Microbiology in Space
1 of 124
“Microcosmic Odyssey” by Lindy Mangrum - 1st Place.JPG
“Microcosmic Odyssey” by Lindy Mangrum - 1st Place
2 of 124
“Star Girl” by Yaeko Farb - 2nd Place.JPG
“Star Girl” by Yaeko Farb - 2nd Place
3 of 124
“Amazing Galaxy” by Lynette Juarez - 3rd Place.JPG
“Amazing Galaxy” by Lynette Juarez - 3rd Place
4 of 124
“The Final Frontier” by Austen Gleave - Honorable Mention.JPG
“The Final Frontier” by Austen Gleave - Honorable Mention
5 of 124
“Tardigradein Space” by Kate Meredith - Honorable Mention.JPG
“Tardigradein Space” by Kate Meredith - Honorable Mention
6 of 124
“New Frontiers” by Maddison Anderson - Honorable Mention.JPG
“New Frontiers” by Maddison Anderson - Honorable Mention
7 of 124
“Dude”by Rebecca Gearhart, - Honorable Mention.JPG
“Dude”by Rebecca Gearhart, - Honorable Mention
8 of 124
“B. Cereus” by Hannah Crawford - Honorable Mention.JPG
“B. Cereus” by Hannah Crawford - Honorable Mention
9 of 124
“Astro-cell” by Paige Blumer - Honorable Mention.JPG
“Astro-cell” by Paige Blumer - Honorable Mention
10 of 124
“Astrobacterial” by Emily Ferkin - Honorable Mention.JPG
“Astrobacterial” by Emily Ferkin - Honorable Mention
11 of 124
Kate Thayer - Honorable Mention.JPG
Kate Thayer - Honorable Mention
12 of 124
Jacob Henrie - Honorable Mention.JPG
By Jacob Henrie - Honorable Mention
13 of 124
Danielle Thornton - Honorable Mention.JPG
Danielle Thornton - Honorable Mention
14 of 124
F201.JPG
15 of 124
F128.JPG
16 of 124
F123.JPG
17 of 124
F122.JPG
18 of 124
F121.JPG
19 of 124
F119.JPG
20 of 124
F118.JPG
21 of 124
F117.JPG
22 of 124
F116.JPG
23 of 124
F115.JPG
24 of 124
F233.JPG
25 of 124
F113.JPG
26 of 124
F139.JPG
27 of 124
F137.JPG
28 of 124
F136.JPG
29 of 124
F135.JPG
30 of 124
F220.JPG
31 of 124
F134.JPG
32 of 124
F133.JPG
33 of 124
F132.JPG
34 of 124
F131.JPG
35 of 124
F130.JPG
36 of 124
F23_unnumbered_3.JPG
37 of 124
F148.JPG
38 of 124
F164.JPG
39 of 124
F163.JPG
40 of 124
F162.JPG
41 of 124
F160.JPG
42 of 124
F158.JPG
43 of 124
F125.JPG
44 of 124
F157.JPG
45 of 124
F23_unnumbered_1.JPG
46 of 124
F156.JPG
47 of 124
F155.JPG
48 of 124
F154.JPG
49 of 124
F152.JPG
50 of 124
F150.JPG
51 of 124
F165.JPG
52 of 124
F223.JPG
53 of 124
F196.JPG
54 of 124
F166.JPG
55 of 124
F167.JPG
56 of 124
F168.JPG
57 of 124
F170.JPG
58 of 124
F248.JPG
59 of 124
F171.JPG
60 of 124
F172.JPG
61 of 124
F23_unnumbered_2.JPG
62 of 124
F173.JPG
63 of 124
F174.JPG
64 of 124
F176.JPG
65 of 124
F177.JPG
66 of 124
F178.JPG
67 of 124
F180.JPG
68 of 124
F169.JPG
69 of 124
F181.JPG
70 of 124
F186.JPG
71 of 124
F187.JPG
72 of 124
F188.JPG
73 of 124
F191.JPG
74 of 124
F192.JPG
75 of 124
F193.JPG
76 of 124
F195.JPG
77 of 124
F194.JPG
78 of 124
F206.JPG
79 of 124
F138.JPG
80 of 124
F198.JPG
81 of 124
F199.JPG
82 of 124
F202.JPG
83 of 124
F203.JPG
84 of 124
F204.JPG
85 of 124
F205.JPG
86 of 124
F200.JPG
87 of 124
F211.JPG
88 of 124
F213.JPG
89 of 124
F215.JPG
90 of 124
F216.JPG
91 of 124
F217.JPG
92 of 124
F207.JPG
93 of 124
F197.JPG
94 of 124
F208.JPG
95 of 124
F210.JPG
96 of 124
F218.JPG
97 of 124
F219.JPG
98 of 124
F221.JPG
99 of 124
F222.JPG
100 of 124
F182.JPG
101 of 124
F224.JPG
102 of 124
F225.JPG
103 of 124
F226.JPG
104 of 124
F244.JPG
105 of 124
F232.JPG
106 of 124
F231.JPG
107 of 124
F230.JPG
108 of 124
F229.JPG
109 of 124
F153.JPG
110 of 124
F228.JPG
111 of 124
F227.JPG
112 of 124
F129.JPG
113 of 124
F23_unnumbered_5.JPG
114 of 124
F23_unnumbered_4.JPG
115 of 124
F242.JPG
116 of 124
F243.JPG
117 of 124
F249.JPG
118 of 124
F251.JPG
119 of 124
F236.JPG
120 of 124
F237.JPG
121 of 124
F238.JPG
122 of 124
F239.JPG
123 of 124
F240.JPG
124 of 124
F241.JPG
1
of
124
Agar Art Winter 2023 - Tragic Love Stories

1 of 123
"Romeo and Juliet"- Jeonga Gu
"Romeo and Juliet"- Jeonga Gu

2 of 123
69c
"Goerge Padley & Sarah Franks"- Rebecca Ellingson

3 of 123
106c
"3:16"- Maddison Anderson

4 of 123
141c
"Together in heaven- R&J"-Lynette Juarez

5 of 123
99c
Zach Eliason

6 of 123
17c
"Goldfish and Cat" - Jenny Lines

7 of 123
47c
April Hanson

8 of 123
32c
"Anakin... you're breaking my heart..." -Christian Packer

9 of 123
19g
"Winnie the Pooh"- Valerie McGhie

10 of 123
34c
Elizabeth Wagstaff

11 of 123
20c
"The hedgehog and his balloon"- Hannah Crafword

12 of 123
13c
"A walk to remember" -Valerie McGhie

13 of 123
47c
April Hanson

14 of 123
6c
"Two lovers- Sidney Wride"

15 of 123
1g
"Be strong, saith my heart"- Amanda Judd

16 of 123
2g

17 of 123
4c

18 of 123
5c

19 of 123
6c

20 of 123
7c

21 of 123
8g

22 of 123
10c

23 of 123
11c (zoom)

24 of 123
12g

25 of 123
15g

26 of 123
16c (zoom)

27 of 123
26g

28 of 123
21c

29 of 123
Bob-G

30 of 123
Bob-C

31 of 123
38c

32 of 123
49c

33 of 123
33c

34 of 123
29c
35 of 123
28c.JPG

36 of 123
23c

37 of 123
25c

38 of 123
43c

39 of 123
14c

40 of 123
27c

41 of 123
18c

42 of 123
42c

43 of 123
31c
44 of 123
40c

45 of 123
30c

46 of 123
44c

47 of 123
37c

48 of 123
41c
49 of 123
45c

50 of 123
50c

51 of 123
52c
52 of 123
51c

53 of 123
56c (zoom)

54 of 123
48c

55 of 123
46c

56 of 123
53c

57 of 123
55c

58 of 123
54c
59 of 123
147c

60 of 123
146g

61 of 123
144c (zoom)

62 of 123
143c

63 of 123
142c

64 of 123
111c

65 of 123
110c

66 of 123
109c

67 of 123
107c

68 of 123
104c

69 of 123
102c

70 of 123
101c

71 of 123
100g

72 of 123
98g

73 of 123
97g

74 of 123
96c

75 of 123
94c

76 of 123
93c

77 of 123
91c

78 of 123
88c

79 of 123
87c

80 of 123
85c

81 of 123
84c
82 of 123
83c

83 of 123
82c

84 of 123
81g

85 of 123
80c (zoom)

86 of 123
79c

87 of 123
78g

88 of 123
77g

89 of 123
76c

90 of 123
75c

91 of 123
74g

92 of 123
73c

93 of 123
72c

94 of 123
71c

95 of 123
70c

96 of 123
68c (zoom)

97 of 123
67c

98 of 123
66c

99 of 123
65c

100 of 123
64c

101 of 123
63c

102 of 123
62c

103 of 123
61c

104 of 123
60c

105 of 123
59c

106 of 123
58g

107 of 123
57c

108 of 123
3c

109 of 123
24c

110 of 123
39c

111 of 123
36c

112 of 123
59c

113 of 123
57c

114 of 123
90c

115 of 123
89c

116 of 123
86c

117 of 123
95c

118 of 123
92c

119 of 123
108c

120 of 123
35g

121 of 123
145c

122 of 123
103c

123 of 123
105c
1
of
123
Agar Art Fall 2022

1 of 79
Maura Brumbaugh - 1st Place
Maura Brumbaugh - 1st Place

2 of 79
Melina Shurtleff - 2nd Place
Melina Shurtleff - 2nd Place

3 of 79
Sydney Wride - 3rd Place
Sydney Wride - 3rd Place

4 of 79
Sydney Wride - 3rd Place
Sydney Wride - 3rd Place

5 of 79
Eliza Lay - Honorable Mention
Eliza Lay - Honorable Mention

6 of 79
Lynette Juarez - Honorable Mention
Lynette Juarez - Honorable Mention

7 of 79
Payden Mouritsen - Honorable Mention
Payden Mouritsen - Honorable Mention

8 of 79
Jonathan Harrell - Honorable Mention
Jonathan Harrell - Honorable Mention

9 of 79
Elizabeth Bailey - Honorable Mention
Elizabeth Bailey - Honorable Mention

10 of 79
Lindy Magnum - Honorable Mention
Lindy Magnum - Honorable Mention

11 of 79
Rachel Cannon - Honorable Mention
Rachel Cannon - Honorable Mention

12 of 79
Elizabeth Wagstaff - Honorable Mention
Elizabeth Wagstaff - Honorable Mention

13 of 79
Zach Eliason - Honorable Mention
Zach Eliason - Honorable Mention

14 of 79
Valerie McGhie - Honorable Mention
Valerie McGhie - Honorable Mention

15 of 79
Bronte Preece - Honorable Mention
Bronte Preece - Honorable Mention

16 of 79
89_jl.jpg
J.L.
17 of 79
88_vm.jpg
V.M.

18 of 79
86_vg.jpg
V.G.
19 of 79
84_de.jpg
D.E.

20 of 79
83_jc.jpg
J.C.

21 of 79
82_ms.jpg
M.S.

22 of 79
80_ht.jpg
H.T.

23 of 79
79_ac.jpg
A.C.

24 of 79
78_bm.jpg
B.M.

25 of 79
77_kl.jpg
K.L.

26 of 79
76_cb.jpg
C.B.

27 of 79
75_kk.jpg
K.K.

28 of 79
74_ms.jpg
M.S.

29 of 79
72_sb.jpg
S.B.

30 of 79
71_sm.jpg
S.M.

31 of 79
70_gb.jpg
G.B.

32 of 79
69_kh.jpg
K.H.

33 of 79
67_tk.jpg
T.K.

34 of 79
66_jr.jpg
J.R.

35 of 79
65_ef.jpg
E.F.

36 of 79
63_gd.jpg
G.D.

37 of 79
61_ad.jpg
A.D.

38 of 79
167_jp.jpg
J.P.

39 of 79
166_tw.jpg
T.W.

40 of 79
164_pa.jpg
P.A.

41 of 79
163_jj.jpg
J.J.

42 of 79
162_mr.jpg
M.R.

43 of 79
161_eg.jpg
E.G.

44 of 79
160_la.jpg
L.A.

45 of 79
159_jl.jpg
J.L.

46 of 79
158_jb.jpg
J.B.

47 of 79
157_al.jpg
A.L.

48 of 79
156_mn.jpg
M.N.

49 of 79
154_id.jpg
I.D.

50 of 79
153_mw.jpg
M.W.

51 of 79
152_md.jpg
M.D.

52 of 79
150_ko.jpg
K.O.

53 of 79
149_ap.jpg
A.P.

54 of 79
148_kh.jpg
K.H.

55 of 79
146_az.jpg
A.Z.

56 of 79
145_rs.jpg
R.S.

57 of 79
143_bs.jpg
B.S.

58 of 79
141_cg.jpg
C.G.
59 of 79
140_er.jpg
E.R.

60 of 79
139_cg.jpg
C.G.

61 of 79
138_as.jpg
A.S.

62 of 79
136_nl.jpg
N.L.

63 of 79
135_bl.jpg
B.L.

64 of 79
134_hw.jpg
H.W.
65 of 79
133-hd.jpg
H.D.

66 of 79
106_sm.jpg
S.M.

67 of 79
104_kc.jpg
K.C.

68 of 79
103_ch.jpg
C.H.

69 of 79
102_sa.jpg
S.A.

70 of 79
101_ks.jpg
K.S.

71 of 79
100_aa.jpg
A.A.

72 of 79
99_no.jpg
N.O.

73 of 79
98_mg.jpg
M.G.

74 of 79
96_kk.jpg
K.K.

75 of 79
95_sm.jpg
S.M.

76 of 79
94_ac.jpg
A.C.

77 of 79
93_nc.jpg
N.C.
78 of 79
92_mj.jpg
M.J.

79 of 79
90_ch.jpg
C.H.
1
of
79
Agar Art Winter 2022

1 of 74
IMG_8127.jpg
mmbio BYU

2 of 74
Second Place_8.jpg
mmbio BYU

3 of 74
Second Place 2.jpg
mmbio BYU

4 of 74
Third Place.jpg
mmbio BYU

5 of 74
IMG_8139.jpg
mmbio BYU

6 of 74
IMG_8137.jpg
mmbio BYU

7 of 74
IMG_8135.jpg
mmbio BYU

8 of 74
H_31.jpg
mmbio BYU

9 of 74
IMG_8134.jpg
mmbio BYU
10 of 74
IMG_8126.jpg
mmbio BYU

11 of 74
IMG_8125.jpg
mmbio BYU

12 of 74
IMG_8122.jpg
mmbio BYU

13 of 74
IMG_8121.jpg
mmbio BYU

14 of 74
IMG_8119.jpg
mmbio BYU

15 of 74
IMG_8118.jpg
mmbio BYU

16 of 74
IMG_8117.jpg
mmbio BYU

17 of 74
IMG_8116.jpg
mmbio BYU

18 of 74
IMG_8115.jpg
mmbio BYU

19 of 74
IMG_8113.jpg
mmbio BYU

20 of 74
IMG_8112.jpg
mmbio BYU
21 of 74
IMG_8111.jpg
mmbio BYU

22 of 74
IMG_8109.jpg
mmbio BYU

23 of 74
IMG_8108.jpg
mmbio BYU

24 of 74
IMG_8107.jpg
mmbio BYU

25 of 74
IMG_8106.jpg
mmbio BYU

26 of 74
IMG_8105.jpg
mmbio BYU

27 of 74
IMG_8104.jpg
mmbio BYU

28 of 74
IMG_8103.jpg
mmbio BYU

29 of 74
IMG_8102.jpg
mmbio BYU

30 of 74
IMG_8101.jpg
mmbio BYU

31 of 74
IMG_8100.jpg
mmbio BYU

32 of 74
IMG_8099.jpg
mmbio BYU

33 of 74
IMG_8098.jpg
mmbio BYU

34 of 74
IMG_8097.jpg
mmbio BYU

35 of 74
IMG_8096.jpg
mmbio BYU

36 of 74
IMG_8094.jpg
mmbio BYU

37 of 74
IMG_8093.jpg
mmbio BYU

38 of 74
IMG_8092.jpg
mmbio BYU

39 of 74
IMG_8091.jpg
mmbio BYU

40 of 74
IMG_8090.jpg
mmbio BYU

41 of 74
IMG_8089.jpg
mmbio BYU
42 of 74
IMG_8087.jpg
mmbio BYU

43 of 74
IMG_8086.jpg
mmbio BYU

44 of 74
IMG_8085.jpg
mmbio BYU

45 of 74
IMG_8084.jpg
mmbio BYU

46 of 74
IMG_8083.jpg
mmbio BYU

47 of 74
IMG_8082.jpg
mmbio BYU

48 of 74
IMG_8081.jpg
mmbio BYU
49 of 74
IMG_8160.jpg
mmbio BYU

50 of 74
Lincoln_Sutherland.jpg

51 of 74
IMG_8158.jpg
mmbio BYU

52 of 74
IMG_8157.jpg
mmbio BYU

53 of 74
IMG_8156.jpg
mmbio BYU

54 of 74
IMG_8155.jpg
mmbio BYU

55 of 74
IMG_8154.jpg
mmbio BYU

56 of 74
IMG_8153.jpg
mmbio BYU

57 of 74
IMG_8152.jpg
mmbio BYU

58 of 74
IMG_8148.jpg
mmbio BYU

59 of 74
Thomas_Armond.jpg
mmbio BYU

60 of 74
IMG_8146.jpg
mmbio BYU

61 of 74
IMG_8145.jpg
mmbio BYU

62 of 74
IMG_8051.jpg

63 of 74
IMG_8041.jpg

64 of 74
IMG_8042.jpg

65 of 74
IMG_8043.jpg

66 of 74
IMG_8044.jpg

67 of 74
IMG_8045.jpg

68 of 74
IMG_8046.jpg

69 of 74
IMG_8047.jpg

70 of 74
IMG_8048.jpg

71 of 74
IMG_8049.jpg
72 of 74
IMG_8050.jpg

73 of 74
IMG_8040.jpg

74 of 74
IMG_8039.jpg
1
of
74
Agar Art Fall 2021
1 of 202
Godzilla 2021
2 of 202
3C0A7686.JPG
3 of 202
2.JPG
4 of 202
21.JPG
5 of 202
19.JPG
6 of 202
18.JPG
7 of 202
16.JPG
8 of 202
14.JPG
9 of 202
13.JPG
10 of 202
23.JPG
11 of 202
22.JPG
12 of 202
24.JPG
13 of 202
37.JPG
14 of 202
25.JPG
15 of 202
26.JPG
16 of 202
27.JPG
17 of 202
28.JPG
18 of 202
29.JPG
19 of 202
36.JPG
20 of 202
35.JPG
21 of 202
34.JPG
22 of 202
20.JPG
23 of 202
33.JPG
24 of 202
32.JPG
25 of 202
31.JPG
26 of 202
30.JPG
27 of 202
61.JPG
28 of 202
60.JPG
29 of 202
59.JPG
30 of 202
58.JPG
31 of 202
57.JPG
32 of 202
56.JPG
33 of 202
55.JPG
34 of 202
54.JPG
35 of 202
53.JPG
36 of 202
52.JPG
37 of 202
51.JPG
38 of 202
50.JPG
39 of 202
49.JPG
40 of 202
48.JPG
41 of 202
47.JPG
42 of 202
46.JPG
43 of 202
45.JPG
44 of 202
44.JPG
45 of 202
43.JPG
46 of 202
42.JPG
47 of 202
41.JPG
48 of 202
40.JPG
49 of 202
39.JPG
50 of 202
38.JPG
51 of 202
85.JPG
52 of 202
84.JPG
53 of 202
83.JPG
54 of 202
82.JPG
55 of 202
81.JPG
56 of 202
80.JPG
57 of 202
79.JPG
58 of 202
78.JPG
59 of 202
77.JPG
60 of 202
76.JPG
61 of 202
75.JPG
62 of 202
74.JPG
63 of 202
73.JPG
64 of 202
72.JPG
65 of 202
71.JPG
66 of 202
70.JPG
67 of 202
69.JPG
68 of 202
68.JPG
69 of 202
67.JPG
70 of 202
66.JPG
71 of 202
65.JPG
72 of 202
64.JPG
73 of 202
63.JPG
74 of 202
62.JPG
75 of 202
109.JPG
76 of 202
108.JPG
77 of 202
107.JPG
78 of 202
106.JPG
79 of 202
105.JPG
80 of 202
104.JPG
81 of 202
1.JPG
82 of 202
103.JPG
83 of 202
102.JPG
84 of 202
101.JPG
85 of 202
100.JPG
86 of 202
99.JPG
87 of 202
98.JPG
88 of 202
97.JPG
89 of 202
96.JPG
90 of 202
95.JPG
91 of 202
94.JPG
92 of 202
93.JPG
93 of 202
92.JPG
94 of 202
91.JPG
95 of 202
90.JPG
96 of 202
89.JPG
97 of 202
88.JPG
98 of 202
87.JPG
99 of 202
86.JPG
100 of 202
134.JPG
101 of 202
133.JPG
102 of 202
132.JPG
103 of 202
131.JPG
104 of 202
130.JPG
105 of 202
129.JPG
106 of 202
128.JPG
107 of 202
127.JPG
108 of 202
126.JPG
109 of 202
125.JPG
110 of 202
124.JPG
111 of 202
123.JPG
112 of 202
121.JPG
113 of 202
120.JPG
114 of 202
119.JPG
115 of 202
118.JPG
116 of 202
117.JPG
117 of 202
116.JPG
118 of 202
115.JPG
119 of 202
114.JPG
120 of 202
113.JPG
121 of 202
112.JPG
122 of 202
111.JPG
123 of 202
110.JPG
124 of 202
158.JPG
125 of 202
157.JPG
126 of 202
156.JPG
127 of 202
155.JPG
128 of 202
154.JPG
129 of 202
153.JPG
130 of 202
152.JPG
131 of 202
151.JPG
132 of 202
150.JPG
133 of 202
149.JPG
134 of 202
148.JPG
135 of 202
147.JPG
136 of 202
146.JPG
137 of 202
145.JPG
138 of 202
144.JPG
139 of 202
143.JPG
140 of 202
142.JPG
141 of 202
141.JPG
142 of 202
140.JPG
143 of 202
139.JPG
144 of 202
138.JPG
145 of 202
137.JPG
146 of 202
136.JPG
147 of 202
135.JPG
148 of 202
182.JPG
149 of 202
181.JPG
150 of 202
180.JPG
151 of 202
179.JPG
152 of 202
178.JPG
153 of 202
177.JPG
154 of 202
176.JPG
155 of 202
175.JPG
156 of 202
174.JPG
157 of 202
173.JPG
158 of 202
172.JPG
159 of 202
171.JPG
160 of 202
170.JPG
161 of 202
169.JPG
162 of 202
168.JPG
163 of 202
167.JPG
164 of 202
166.JPG
165 of 202
165.JPG
166 of 202
164.JPG
167 of 202
163.JPG
168 of 202
162.JPG
169 of 202
161.JPG
170 of 202
160.JPG
171 of 202
159.JPG
172 of 202
194.JPG
173 of 202
193.JPG
174 of 202
192.JPG
175 of 202
191.JPG
176 of 202
190.JPG
177 of 202
188.JPG
178 of 202
189.JPG
179 of 202
187.JPG
180 of 202
186.JPG
181 of 202
185.JPG
182 of 202
184.JPG
183 of 202
183.JPG
184 of 202
203.JPG
185 of 202
202.JPG
186 of 202
201.JPG
187 of 202
200.JPG
188 of 202
199.JPG
189 of 202
198.JPG
190 of 202
197.JPG
191 of 202
196.JPG
192 of 202
195.JPG
193 of 202
First Presidency.JPG
194 of 202
209.JPG
195 of 202
208.JPG
196 of 202
207.JPG
197 of 202
11.JPG
198 of 202
7.JPG
199 of 202
8.JPG
200 of 202
10.JPG
201 of 202
9.JPG
202 of 202
209.JPG
1
of
202